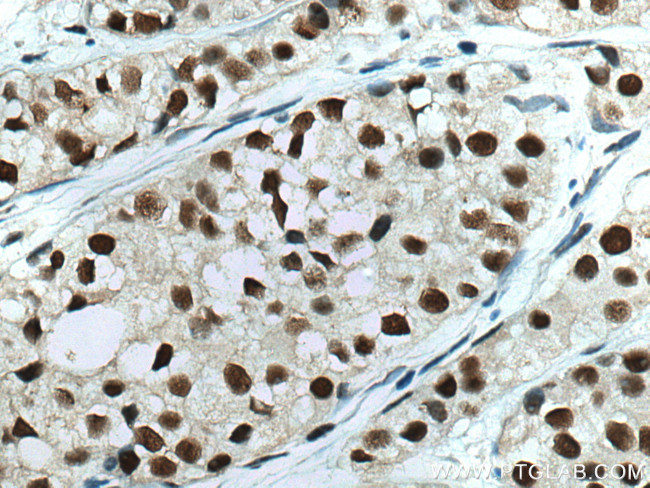
HSF1 Antibody in Immunohistochemistry (Paraffin) (IHC (P))

Search
Proteintech
HSF1 Monoclonal Antibody (1F10A5)
{{$productOrderCtrl.translations['antibody.pdp.commerceCard.promotion.promotions']}}
{{$productOrderCtrl.translations['antibody.pdp.commerceCard.promotion.viewpromo']}}
{{$productOrderCtrl.translations['antibody.pdp.commerceCard.promotion.promocode']}}: {{promo.promoCode}} {{promo.promoTitle}} {{promo.promoDescription}}. {{$productOrderCtrl.translations['antibody.pdp.commerceCard.promotion.learnmore']}}
产品信息
67189-1-IG
种属反应
宿主/亚型
分类
类型
克隆号
抗原
偶联物
形式
浓度
规格
纯化类型
保存液
内含物
保存条件
运输条件
产品详细信息
Aliquoting is unnecessary for -20°C storage.
靶标信息
All organisms respond to elevated temperatures and a variety of environmental stresses by rapid synthesis of heat shock RNAs and proteins. The regulation of heat shock gene transcription is mediated by the transcriptional activator, heat shock factor (HSF), which binds to heat shock response elements (HSEs). These HSEs are found as three repeats of a 5-nucleotide {nGAAn} module, arranged in alternating orientation and present upstream of all heat shock genes. The HSEs are highly conserved among species yet HSF purified from yeast, Drosophila and human have different molecular weights and the proteins do not show significant immunological cross reaction. Two HSFs have been identified in human cells, HSF1 and HSF2, which bind to the same HSEs and have 38% sequence identity. These factors are activated by distinct stimuli, HSF1 is responsive to classical stress signals such as heat, heavy metals and oxidative reagents, whereas HSF2 is activated during hemin-mediated differentiation of human erythroleukemia cells. HSF1 exists constitutively in the cytoplasm and the nucleus of unstressed cells as a monomer which lacks DNA binding activity. Through an unknown signal generated during stress, HSF1 becomes activated to a nuclear localized, trimeric state which binds to DNA. The phosphorylation of HSF1 is necessary for maximal transcription of heat shock genes.
仅用于科研。不用于诊断过程。未经明确授权不得转售。
生物信息学
蛋白别名: Heat shock factor protein 1; Heat shock transcription factor 1; heat shock transcription factor 1 alpha isoform; heat shock transcription factor 1 beta isoform; heat shock transcription factor 1 gammaalpha isoform; heat shock transcription factor 1 gammabeta isoform; HSF 1; HSF1; Hsf1gammaalpha; Hsf1gammabeta; HSTF 1; unnamed protein product
基因别名: AA960185; HSF1; Hsf1alpha; Hsf1beta; HSTF1
UniProt ID: (Human) Q00613, (Mouse) P38532
Entrez Gene ID: (Human) 3297, (Rat) 79245, (Mouse) 15499